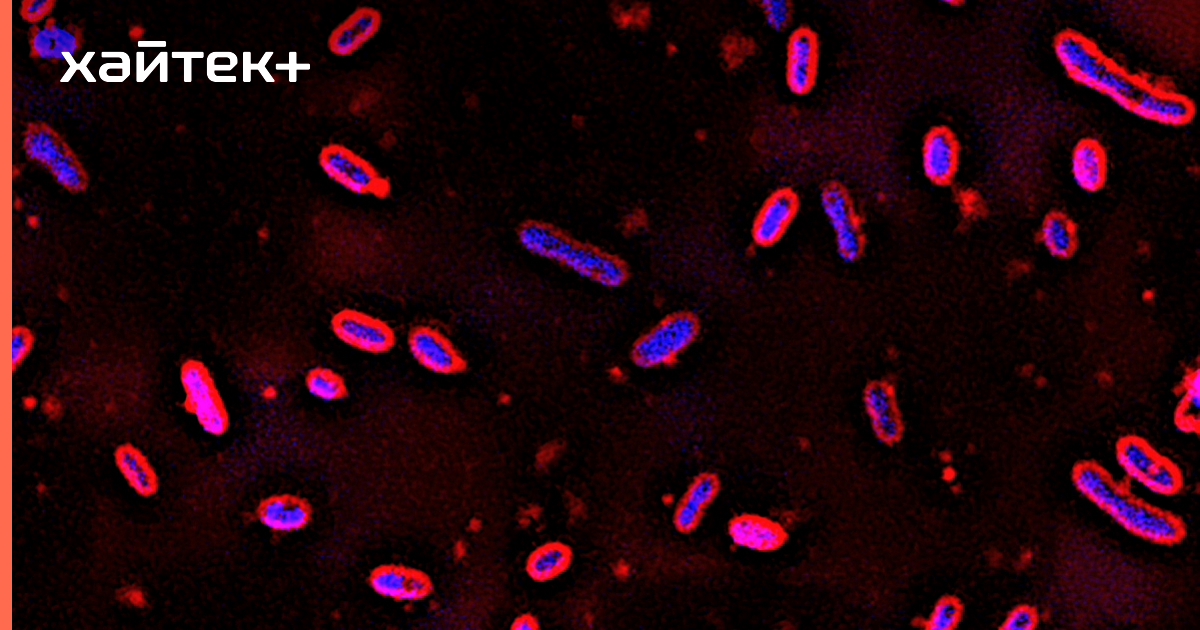

Генно модифицированные бактерии
Nise easy дарьи
Улица физрук
Левенцовская крепость
Парашют из картона
Один из авторов версальского мирного договора
Park ps1
Шины icon nordman зимние отзывы
Завод литмаш
Дружба 15 нижневартовск
Предварительный прогноз на зиму 2025
Коробка на ниссан сентра
Серозометра как лечить
Фенол влияние на человека
Генно модифицированные бактерии 115 фотографий